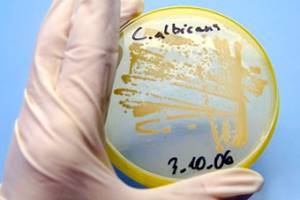

Эраксис инструкция, аналоги и состав
| Показания: | Інвазивний кандидоз у дорослих пацієнтів. |
| Форма випуска: | Порошок для розчину для інфузій по 100 мг у флаконах № 1 |
| Производитель, страна: | Фармація і Апджон Компані, США |
| Действующее вещества: | 1 флакон містить анідулафунгіну 100 мг |
| МНН: | Anidulafungin - Анидулафунгин |
| Регистрация: | UA/12190/01/01з 08.06.2012 по 08.06.2017. Приказ 195 від 16.03.2016 |
| Код АТХ: |
Склад:
діюча речовина:анідулафунгін;
1 флакон містить анідулафунгіну 100 мг;
допомiжнi речовини: фруктоза, маніт (Е 421), полісорбат 80, кислота винна.
Лікарська форма. Порошок для розчину для інфузій.
Основні фізико-хімічні властивості:від білого до майже білого кольору ліофілізований порошок у прозорому флаконі зі скла ємкістю 30 мл, закупореному 20 мм пробкою сірого кольору та алюмінієвою пломбою із системою flip-off.
Фармакотерапевтична група. Протигрибкові засоби для системного застосування.
Код АТХ J02A X06.
Фармакологічні властивості.
Фармакодинаміка.
Механізм дії.
Анідулафунгін – напівсинтетичний ехінокандин, ліпопептид, синтезований при ферментації продуктів Aspergillus nidulans. Анідулафунгін вибірково пригнічує синтазу 1,3-β-D глюкану – важливого ферменту грибкової клітини, що відсутній у клітинах ссавців. Це призводить до порушення формування 1,3-β-D-глюкану, основного компонента стінки грибкової клітини. Анідулафунгін має фунгіцидну активність проти різних видів грибів роду Сandida та активність у ділянках активного росту клітин гіфів гриба Aspergillus fumigatus.
Активність in vitro.
Анідулафунгін проявляв активність in vitro стосовно C. albicans, C. glabrata, C. parapsilosis,
C. krusei і C. tropicalis. Клінічну значущість цих даних описано нижче («Клінічна ефективність і безпека»).
Штами з мутаціями в зонах «гарячих точок» гена-мішені не піддавалися терапії або характеризувалися як стійкі інфекції. У більшості клінічних випадків застосовували каспофунгін. Однак у експериментах на тваринах ці мутації надають перехресної стійкості до всіх трьох ехінокандинів і тому такі штами класифікуються як стійкі до ехінокандинів, доки не отримано нового клінічного досвіду щодо анідулафунгіну.
Активність анідулафунгіну in vitro проти різних видів Candida несхожа. А саме, мінімальні пригнічувальні концентрації (МПК) анідулафунгіну стосовно C. parapsilosis вищі, ніж до інших видів Candida. Європейський комітет з визначення чутливості до антимікробних засобів (EUCAST) запровадив стандартизовану методику визначення чутливості видів Candida до анідулафунгіну, а також встановив відповідні орієнтувальні граничні концентрації.
Граничні концентрації, встановлені EUCAST
|
Види Candida |
Гранична МПК (мг/л) |
|
|
≤S (чутливий) |
>R (резистентний) |
|
|
Candida albicans |
0,03 |
0,03 |
|
Candida glabrata |
0,06 |
0,06 |
|
Candida tropicalis |
0,06 |
0,06 |
|
Candida krusei |
0,06 |
0,06 |
|
Candida parapsilosis1 |
0,002 |
4 |
|
Інші види Candida2 |
Недостатньо даних |
|
|
1 Можливою причиною більш високої мінімальної пригнічувальної концентрації (МПК) для C. parapsilosis, ніж для інших видів Candida, є притаманна згаданому виду зміна гена, який є мішенню антимікробних засобів. У клінічних дослідженнях результат терапії C. parapsilosis анідулафунгіном статистично не відрізнявся від терапії інших видів, проте застосування ехінокандинів не можна вважати терапією першої лінії при кандидемії через C. parapsilosis. 2 EUCAST не встановив не залежні від виду пограничні концентрації для анідулафунгіну. |
||
Активність in vivo.
При парентеральному введенні анідулафунгін був ефективний проти грибів видів Candida, що було продемонстровано на моделях імунокомпетентних та імуноскомпрометованих мишей та кролів. Застосування анідулафунгіну збільшувало виживаність у тварин, а також знижувало навантаження органів видами роду Candida при визначенні у період від 24 до 96 годин після останнього введення препарату.
Клінічна ефективність і безпека.
Кандидемія та інші форми інвазивного кандидозу.
Безпеку та ефективність анідулафунгіну оцінювали в базовому рандомізованому подвійному сліпому багатоцентровому міжнародному дослідженні фази 3 за участю пацієнтів з первинною відсутністю нейтропенії, які мали кандидемію, а також за участю обмеженої кількості пацієнтів з кандидозом глибоких тканин або із захворюванням, при якому утворюється абсцес. Пацієнти з кандидозним ендокардитом, остеомієлітом або менінгітом або ж ті, у кого інфекція була спричинена видом C. krusei, були спеціально виключені з дослідження. Пацієнти були рандомізовані для отримання або анідулафунгіну (застосування внутрішньовенної навантажувальної дози 200 мг, після якої застосували 100 мг внутрішньовенно 1 раз на добу), або флуконазолу (застосування внутрішньовенної навантажувальної дози 800 мг, після якої застосували 400 мг внутрішньовенно 1 раз на добу) і стратифіковані за шкалою APACHE II ((≤20 і >20) і наявністю чи відсутністю нейтропенії. Лікування застосовували щонайменше 14 діб і не довше 42 діб. Пацієнтам в обох групах дослідження було дозволено перейти на пероральне застосування флуконазолу після щонайменше 10 діб внутрішньовенної терапії за умов, що вони були здатні переносити пероральний лікарський засіб і не мали підвищеної температури щонайменше 24 години, а їх останні аналізи крові на культури патогенів були негативними щодо видів Candida.
Пацієнти, які застосували щонайменше одну дозу досліджуваного лікарського засобу і які перед початком дослідження виявилися позитивними щодо видів Candida за результатами аналізу на культури з місця, яке звичайно стерильне, були включені в модифіковану популяцію дослідження, куди увійшли всі пацієнти, які отримували лікування (MITT-популяція). У первинному аналізі ефективності, у якому оцінювалася повна відповідь MITT-популяції наприкінці внутрішньовенної терапії, анідулафунгін порівнювали з флуконазолом у ході попередньо заданого двоетапного статистичного порівняння (спочатку застосовували підхід відсутності переваги, а потім підхід переваги). Успішна повна відповідь повинна була включати клінічне покращення та усунення мікробного патогену. За пацієнтами спостерігали впродовж 6 тижнів після закінчення всієї терапії.
256 пацієнтів віком від 16 до 91 року були рандомізовані для лікування і отримали щонайменше одну дозу досліджуваного лікарського засобу. Найбільш поширеним видом серед тих, що були виділені на початковому рівні, виявився C. albicans (63,8 % у групі анідулафунгіну та 59,3 % у групі флуконазолу). Менш поширеними були C. glabrata (15,7 %, 25,4 %), C. parapsilosis (10,2 %, 13,6 %) і C. tropicalis (11,8 %, 9,3 %), причому в групі анідулафунгіну виявилося 20, 13 і 15 штамів трьох останніх видів відповідно. У більшості пацієнтів бал за шкалою Apache II був ≤20, і було дуже мало пацієнтів з нейтропенією.
Дані щодо ефективності, як для всієї сукупності, так і для різних підгруп, представлені в таблиці 1.
Таблиця 1. Успішна повна відповідь у MITT-популяції: первинні та вторинні кінцеві точки
|
Анідулафунгін |
Флуконазол |
Міжгрупова різниця а ( 95% ДІ) |
|
|
Закінчення ВВ терапії (кінцева точка 1) |
96/127 (75,6 %) |
71/118 (60,2 %) |
15,42 (3,9; 27,0) |
|
Лише кандидемія |
88/116 (75,9 %) |
63/103 (61,2 %) |
14,7 (2,5; 26,9) |
|
Інші стерильні місцяб |
8/11 (72,7 %) |
8/15 (53,3 %) |
- |
|
Перитонеальна рідина / в/чв абсцес |
6/8 |
5/8 |
|
|
Інше |
2/3 |
3/7 |
|
|
C. albicansг |
60/74 (81,1 %) |
38/61 (62,3 %) |
- |
|
Види, що не є С. albicans г |
32/45 (71,1 %) |
27/45 (60,0 %) |
- |
|
Бал за шкалою Apache II ≤20 |
82/101 (81,2 %) |
60/98 (61,2 %) |
- |
|
Бал за шкалою Apache II >20 |
14/26 (53,8 %) |
11/20 (55,0 %) |
- |
|
Без нейтропенії (АЧН (абсолютне число нейтрофілів), клітин/мм3 >500) |
94/124 (75,8 %) |
69/114 (60,5 %) |
- |
|
З нейтропенією (АЧН, клітин/мм3 ≤500) |
2/3 |
2/4 |
- |
|
У інших кінцевих точках |
|||
|
Закінчення всієї терапії |
94/127 (74,0 %) |
67/118 (56,8 %) |
17,24 (2.9, 31.6)д |
|
2-тижневе подальше спостереження |
82/127 (64,6 %) |
58/118 (49,2 %) |
15,41 (0,4; 30,4)д |
|
6-тижневе подальше спостереження |
71/127 (55,9 %) |
52/118 (44,1 %) |
11.84 (-3,4; 27,0)д |
а Розрахунок: анідулафунгін мінус флуконазол.
б Із супутньою кандидемією або без неї.
в Внутрішньочеревний.
г Дані представлені для пацієнтів з одиничним патогеном на початковому рівні.
д 98,3 % довірчі інтервали, які були надалі відкориговані для множинних порівнянь вторинних моментів часу.
Летальність в обох групах (анідулафунгін і флуконазол) представлена нижче в таблиці 2:
Таблиця 2. Летальність
|
Анідулафунгін |
Флуконазол |
|
|
Загальна летальність у дослідженні |
29/127 (22,8 %) |
37/118 (31,4 %) |
|
Летальність під час терапії, що досліджувалась |
10/127 (7,9 %) |
17/118 (14,4 %) |
|
Летальність, яка вважається наслідком інфекції Сandida |
2/127 (1,6 %) |
5/118 (4,2 %) |
Додаткові дані щодо пацієнтів з нейтропенією
Ефективність анідулафунгіну (під час застосування внутрішньовенної навантажувальної дози
200 мг, після якої 100 мг лікарського засобу застосовували внутрішньовенно 1 раз на добу) для дорослих пацієнтів з нейтропенією (яка визначається за критеріями: абсолютне число нейтрофілів ≤ 500 кл/мм3, лейкоцити ≤ 500 кл/мм3 або пацієнт класифікується дослідником як такий, що має нейтропенію на початковому рівні) з мікробіологічно підтвердженим інвазивним кандидозом оцінювали шляхом аналізу об'єднаних даних із 5 проспективних досліджень (одне порівняльне проти каспофунгіну і чотири відкритих непорівняльних). Терапія для пацієнтів тривала щонайменше 14 діб. Для клінічно стабільних пацієнтів перехід на пероральну азольну терапію дозволявся після терапії анідулафунгіном, яку проводили упродовж щонайменше від 5 до 10 діб. Усього 46 пацієнтів були включені в цей аналіз. Більшість пацієнтів мали лише кандидемію (84,8 %; 39/46). Найбільш поширеними патогенами серед тих, що були виділені на початковому рівні, виявилися C. tropicalis (34,8 %; 16/46), C. krusei (19,6 %; 9/46), C. parapsilosis (17,4 %; 8/46), C. albicans (15,2 %; 7/46) і C. glabrata (15,2 %; 7/46). Успішна повна відповідь наприкінці внутрішньовенної терапії (первинна кінцева точка) спостерігалася з частотою 26/46 (56,5 %), а наприкінці всієї терапії – 24/46 (52,2 %). Летальність з усіх причин до кінця дослідження (візит подальшого спостереження на 6-му тижні) становила 21/46 (45,7 %).
Ефективність анідулафунгіну для дорослих пацієнтів з нейтропенією (яка визначалася за критерієм: абсолютне число нейтрофілів ≤500 кл/мм3 на початковому рівні) і з інвазивним кандидозом оцінювали в перспективному подвійному сліпому рандомізованому контрольованому дослідженні. Пацієнти, які відповідали критеріям, отримували або анідулафунгін (внутрішньовенна навантажувальна доза 200 мг, після якої 100 мг лікарського засобу застосували внутрішньовенно 1 раз на добу), або каспофунгін (внутрішньовенна навантажувальна доза 70 мг, після якої 50 мг лікарського засобу застосували внутрішньовенно 1 раз на добу) (рандомізація 2:1). Терапія для пацієнтів тривала щонайменше 14 діб. Для клінічно стабільних пацієнтів перехід на пероральне застосування азолів дозволявся після щонайменше 10-добової терапії досліджуваним лікарським засобом. Загалом 14 пацієнтів з нейтропенією і мікробіологічно підтвердженим інвазивним кандидозом (MITT-популяція) були включені в дослідження (11 у групу анідулафунгіну та 3 – групу каспофунгіну). Більшість пацієнтів мали лише кандидемію. Найбільш поширеними патогенами, виділеними на початковому рівні, були C. tropicalis (4 анідулафунгін, 0 каспофунгін), C. parapsilosis (2 анідулафунгін, 1 каспофунгін), C. krusei (2 анідулафунгін, 1 каспофунгін) і C. ciferrii (2 анідулафунгін, 0 каспофунгін). Успішна повна відповідь наприкінці внутрішньовенної терапії (первинна кінцева точка) спостерігалася з частотою 8/11 (72,7 %) для анідулафунгіну і 3/3 (100,0 %) для каспофунгіну (різниця -27,3; 95 % ДІ-80,9; 40,3); успішна повна відповідь наприкінці всіх видів терапії спостерігалася з частотою 8/11 (72,7 %) для анідулафунгіну і 3/3 (100,0 %) для каспофунгіну (різниця -27,3; 95 % ДІ -80,9; 40,3). Летальність з усіх причин до візиту подальшого спостереження на 6-му тижні становила 4/11 (36,4 %) для анідулафунгіну і 2/3 (66,7 %) для каспофунгіну.
Пацієнти з мікробіологічно підтвердженим інвазивним кандидозом були ідентифіковані в аналізі об'єднаних даних від чотирьох проспективних відкритих непорівняльних досліджень з однаковим дизайном. Ефективність анідулафунгіну (під час застосування внутрішньовенної навантажувальної дози 200 мг, після якої 100 мг лікарського засобу застосовували внутрішньовенно 1 раз на добу) була оцінена для 35 дорослих пацієнтів з нейтропенією, яка у 22 пацієнтів визначалася за критеріями: абсолютне число нейтрофілів ≤500 кл/мм3 або лейкоцитів ≤500 кл/мм3, а 13 пацієнтів були класифіковані дослідником як такі, що мають нейтропенію на початковому рівні. Терапія для всіх пацієнтів тривала щонайменше 14 діб. Для клінічно стабільних пацієнтів перехід на пероральну азольну терапію дозволявся після терапії анідулафунгіном, яку проводили упродовж щонайменше від 5 до 10 діб. Більшість пацієнтів мали лише кандидемію (85,7 %). Найбільш поширеними патогенами, виділеними на початковому рівні, були C. tropicalis (12 пацієнтів), C. albicans (7 пацієнтів), C. glabrata (7 пацієнтів), C. krusei (7 пацієнтів) і C. parapsilosis (6 пацієнтів). Успішна повна відповідь наприкінці внутрішньовенної терапії (первинна кінцева точка) спостерігалася з частотою 18/35 (51,4 %), а наприкінці всіх видів терапії – 16/35 (45,7 %). Летальність з усіх причин до 28-го дня становила 10/35 (28,6 %). Успішна повна відповідь наприкінці внутрішньовенної терапії та наприкінці всіх видів терапії спостерігалася з однаковою частотою 7/13 (53,8 %) у 13 пацієнтів з нейтропенією, які були оцінені дослідником на початковому рівні.
Додаткові дані щодо пацієнтів з інфекціями глибоких тканин
Ефективність анідулафунгіну (під час застосування внутрішньовенної навантажувальної дози 200 мг, після якої 100 мг лікарського засобу застосовували внутрішньовенно 1 раз на добу) для дорослих пацієнтів з мікробіологічно підтвердженим кандидозом глибоких тканин оцінювалася в аналізі об'єднаних даних із п'яти проспективних досліджень (одне порівняльне і чотири відкритих). Терапія для пацієнтів тривала щонайменше 14 діб. У чотирьох відкритих дослідженнях перехід на пероральну азольну терапію дозволявся після терапії анідулафунгіном, яку проводили упродовж щонайменше від 5 до 10 діб. Усього 129 пацієнтів були включені в цей аналіз. Двадцять один з них (16,3 %) мав супутню кандидемію. Середній бал за шкалою APACHE II становив 14,9 (діапазон: 2-44). Найбільш поширені локалізації інфекції включали внутрішньочеревну порожнину (54,3 %; 70 з 129), гепатобіліарний тракт (7,0 %; 9 з 129), плевральну порожнину (5,4 %; 7 з 129) і нирку (3,1 %; 4 з 129). Найбільш поширеними патогенами серед тих, що були виділені на початковому рівні з ділянки в глибоких тканинах, виявилися C. albicans (64,3 %; 83 з 129), C. glabrata (31,0 %; 40 з 129), C. tropicalis (11,6 %; 15 з 129) і C. krusei (5,4 %; 7 з 129). Дані про успішну повну відповідь наприкінці внутрішньовенної терапії (первинна кінцева точка) і наприкінці всієї терапії, а також про летальність з усіх причин до візиту подальшого спостереження на 6-му тижні представлені в таблиці 3.
Таблиця 3. Частота успішної повної відповідіа і летальності з усіх причин серед пацієнтів з кандидозом глибоких тканин – об'єднаний аналіз
|
Модифікована популяція, що отримувала лікування (MITT), n/N ( %) |
||
|
Успішна повна відповідь наприкінці внутрішньовенної терапії (НВВТ) |
||
|
Загалом |
102/129 (79,1 %) |
|
|
Внутрішньочеревна порожнина |
51/70 (72,9 %) |
|
|
Гепатобіліарний тракт |
7/9 (77,8 %) |
|
|
Плевральна порожнина |
6/7 (85,7 %) |
|
|
Нирка |
3/4 (75,0 %) |
|
|
Успішна повна відповідь наприкінці всього курсу терапії (НВТ) |
94/129 (72,9 %) |
|
|
Летальність з усіх причин |
40/129 (31,0 %) |
|
|
а Успішна повна відповідь визначалася як успіх у клінічному і мікробіологічному плані одночасно |
||
Фармакокінетика.
Загальні фармакокінетичні властивості.
Фармакокінетика анідулафунгіну була описана у здорових добровольців, в особливих підгрупах та у хворих людей, які лікувалися анідулафунгіном. При цьому спостерігалася низька міжіндивідуальна варіабельність системної експозиції препарату (коефіцієнт варіації становив ~25%). Стан рівноважної концентрації був досягнутий в першу добу після застосування навантажувальної дози препарату (подвійної підтримуючої дози препарату).
Розподіл.
Фармакокінетика анідулафунгіну характеризується коротким періодом напіврозпаду (0,5-1 год) та об’ємом розподілу величиною 30-50 л, що близький до загального об’єму рідини організму. Анідулафунгін у значній мірі (>99%) зв’язується з білками плазми крові людини. Спеціальних досліджень з вивчення розподілу анідулафунгіну в тканинах організму людини не проводилось. У зв’язку з цим на сьогоднішній день відсутня інформація щодо проникнення анідулафунгіну в спинномозкову рідину та/або через гематоенцефалічний бар’єр.
Біотрансформація.
Печінковий метаболізм анідулафунгіну не спостерігався. Анідулафунгін не є клінічно значущим субстратом, індуктором або інгібітором ізоферментів цитохрому Р450. Малоймовірно, що анідулафунгін проявлятиме клінічно значущий вплив на метаболізм препаратів, які метаболізуються за участю ізоферментів цитохрому Р450.
При фізіологічних рівнях температури та рН анідулафунгін піддається повільному хімічному розпаду до пептидного сполучення з відкритим кільцем, що не має протигрибкової активності. Період напіврозпаду анідулафунгіну in vitro у фізіологічних умовах становить приблизно
24 години. В умовах in vivo сполучення з відкритим кільцем згодом перетворюється до пептидних продуктів розпаду та виводиться з організму в основному за рахунок екскреції з жовчю.
Виведення.
Кліренс анідулафунгіну становить близько 1 л/год. Основна фаза періоду напіввиведення анідулафунгіну становить приблизно 24 години, що відповідає більшій частині профілю «концентрація препарату в плазмі крові – час», а термінальна фаза періоду напіввиведення становить 40-50 годин, що відповідає термінальній елімінаційній фазі цього профілю.
У клінічному дослідженні із застосуванням одноразової дози здоровим особам вводили мічений радіоактивним ізотопом (14С) анідулафунгін (~88 мг). Приблизно 30% введеної радіоактивної дози були виведені з фекаліями більше ніж через 9 днів, з яких менше 10% становив препарат у незміненому вигляді. З сечею виводилося менше 1% введеної дози радіоактивного препарату, що вказує на незначний нирковий кліренс. Через 6 днів після введення препарату концентрації анідулафунгіну упали нижче за нижню межу кількісного визначення. Через 8 тижнів після введення препарату в крові, сечі та фекаліях була виявлена незначна кількість радіоактивних сполук.
Лінійність.
Анідулафунгін має лінійну фармакокінетику в широкому діапазоні доз (15-130 мг) при застосуванні препарату один раз на добу.
Особливі популяції.
Пацієнти з грибковими інфекціями.
Фармакокінетика анідулафунгіну у пацієнтів з грибковими інфекціями є подібною до тієї, що спостерігається у здорових людей, виходячи з результатів популяційних фармакокінетичних аналізів. При застосуванні препарату в добовій дозі 200/100 мг та при швидкості інфузії 1,1 мг/хв рівноважні максимальна (Сmax) та мінімальна (Сmin) концентрації можуть становити приблизно
7 та 3 мг/л відповідно з середнім значенням рівноважної AUC приблизно 110 мг·год/л.
Маса тіла.
Зміни фармакокінетики, що виникали через масу тіла, мали незначні клінічні прояви.
Стать.
Концентрації анідулафунгіну в плазмі крові у здорових чоловіків та жінок були подібними. У дослідженнях багаторазових доз за участю пацієнтів кліренс препарату у чоловіків був дещо швидшим.
Пацієнти літнього віку.
Популяційний фармакокінетичний аналіз показав, що середнє значення кліренсу дещо відрізнялося у групі пацієнтів похилого віку (пацієнти віком ≥65 років; медіана кліренсу становить 1,07 л/год) у порівнянні з групою пацієнтів молодшого віку (пацієнти віком <65 років; медіана кліренсу становить 1,22 л/год), проте діапазон значень кліренсу в цих групах був подібним.
Етнічна приналежність.
Фармакокінетика анідулафунгіну у представників європеоїдної раси, афроамериканців, азіатів та латиноамериканців була подібною.
ВІЛ-позитивні пацієнти.
Незалежно від супутнього застосування антиретровірусної терапії корекція дози препарату у ВІЛ-позитивних пацієнтів без нейтропенії не потрібна.
Печінкова недостатність.
Анідулафунгін не метаболізується у печінці. Фармакокінетика анідулафунгіну вивчалася у пацієнтів з печінковою недостатністю класів А, В і С за класифікацією Чайлда-П’ю. Концентрації анідулафунгіну у пацієнтів з будь-яким ступенем печінкової недостатності не збільшувались. Хоча у пацієнтів з печінковою недостатністю класу С за класифікацією Чайлда-П’ю спостерігалось невелике зменшення AUC, це зменшення було в межах діапазону рівнів AUC, отриманих при вивченні препарату у здорових осіб.
Ниркова недостатність.
Анідулафунгін має незначний нирковий кліренс (<1%). У клінічному дослідженні за участю пацієнтів з легким, помірним та важким ступенем ниркової недостатності або з термінальною стадією ниркової недостатності (діаліз-залежні пацієнти) фармакокінетика анідулафунгіну у цих пацієнтів була подібною до тієї, що спостерігалась у осіб з нормальною нирковою функцією. Анідулафунгін не піддається діалізу і може призначатися незалежно від часу проведення гемодіалізу.
Діти.
Фармакокінетику анідулафунгіну після застосування щонайменше 5 добових доз досліджували у 24 імунокомпрометованих пацієнтів дитячого (2-11 років) і підліткового (12-17 років) віку з нейтропенією. Рівноважний стан досягався в перший день після навантажувальної дози (що у два рази перевищувала підтримуючу дозу), а рівноважні показники Cmax і AUCss підвищувалися пропорційно дозі. Показники системної експозиції після застосування добової підтримуючої дози на рівнях 0,75 і 1,5 мг/кг/добу в цій популяції були зіставними з такими, що спостерігалися в дорослих після 50 і 100 мг/добу відповідно. Обидві схеми добре переносилися цими пацієнтами.
Клінічні характеристики.
Показання.
Інвазивний кандидоз у дорослих пацієнтів.
Протипоказання.
Підвищена чутливість до активної речовини або до інших компонентів препарату.
Підвищена чутливість до інших лікарських засобів класу ехінокандинів.
Взаємодія з іншими лікарськими засобами та інші види взаємодій.
Анідулафунгін не є клінічно значущою субстанцією, індуктором або інгібітором ізоферментів цитохрому Р450 (1А2, 2В6, 2С8, 2С9, 2С19, 2D6, 3A). Слід зазначити, що дослідження in vitro не виключають повністю можливі взаємодії в умовах in vivo.
Проводилися дослідження взаємодії анідулафунгіну з іншими лікарськими засобами, які можуть призначатися одночасно з ним. При спільному застосуванні анідулафунгіну з циклоспорином, вориконазолом або такролімусом корекція дози жодного з цих лікарських засобів не рекомендується; при одночасному застосуванні препарату з амфотерицином В або рифампіцином немає необхідності в корекції дози анідулафунгіну.
Діти.
Дослідження взаємодії лікарських засобів проводилося лише за участю дорослих.
Особливості застосування.
Застосування препарату Ераксис пацієнтами з Candidaendocarditis, остеомієлітом або менінгітом не досліджували.
Ефективність препарату оцінювали лише в умовах його застосування обмеженою кількістю пацієнтів з нейтропенією (див. розділ «Фармакодинаміка»).
Вплив на печінку.
Спостерігалося підвищення рівнів ферментів печінки у здорових добровольців та пацієнтів, які лікувалися анідулафунгіном. У деяких пацієнтів із серйозними основними захворюваннями, які одночасно з анідулафунгіном отримували численні лікарські засоби, спостерігались клінічно значущі порушення з боку печінки. Повідомлялось про поодинокі випадки дисфункції печінки, гепатиту або печінкової недостатності. Пацієнти, у яких на фоні лікування анідулафунгіном спостерігається підвищення рівня печінкових ферментів, мають знаходитись під контролем для своєчасного виявлення ознак погіршення функції печінки та для оцінки ризику/користі продовження терапії анідулафунгіном.
Анафілактичні реакції.
Під час застосування анідулафунгіну повідомлялося про анафілактичні реакції, включаючи шок. У разі виникнення таких реакцій слід відмінити анідулафунгін і застосувати відповідне лікування.
Реакції, пов’язані з інфузійним введенням препарату.
Під час застосування анідулафунгіну були відмічені побічні реакції, пов’язані з інфузійним введенням препарату, які включали висипання, кропив’янку, патологічний рум’янець, свербіж, диспное, бронхоспазм і гіпотензію. Побічні реакції, пов’язані з інфузійним введенням препарату, є нечастими, якщо швидкість інфузії не перевищує 1,1 мг/хв.
У доклінічних дослідженнях спостерігалося посилення реакцій, пов’язаних з інфузійним введенням препарату, при одночасному застосуванні з анестетиками. Клінічна значимість цього явища невідома. Однак, слід проявляти обережність при спільному застосуванні анідулафунгіну та знеболювальних засобів.
Вміст фруктози.
Даний лікарський засіб не слід приймати пацієнтам з рідкісною вродженою непереносимістю фруктози.
Застосування у період вагiтностi або годування груддю.
Анідулафунгін не застосовують у період вагітності.
Невідомо, чи потрапляє анідулафунгін у грудне молоко людини. Рішення щодо продовження/припинення годування груддю чи лікування анідулафунгіном слід приймати, беручи до уваги перевагу від годування груддю для дитини або перевагу від лікування анідулафунгіном для матері.
Здатність впливати на швидкість реакції при керуванні автотранспортом або іншими механізмами.
Спеціальних досліджень щодо впливу препарату на здатність управляти автомобілем та іншими механізмами не проводилося, проте слід брати до уваги інформацію, яка наведена у розділі «Побічні реакції».
Спосіб застосування та дози.
Лікування препаратом Ераксис має бути розпочате лікарем, досвідченим у лікуванні інвазивних грибкових інфекцій. Зразки для виділення грибкової культури мають бути відібрані до початку терапії. Терапія може бути розпочата до отримання результатів дослідження цих зразків та після отримання результатів терапія може бути відповідно скоригована.
Інвазивний кандидозу дорослих пацієнтів.
Лікування розпочинають з разової навантажувальної дози в перший день − 200 мг з наступним введенням 100 мг препарату щодня.
Тривалість лікування залежить від клінічної відповіді пацієнта на терапію. Загалом протигрибкова терапія має бути продовжена протягом щонайменше 14 днів після отримання лабораторних результатів. що підтверджують відсутність грибів.
Тривалість лікування.
Недостатньо даних щодо застосування препарату довше ніж 35 днів із дозуванням у 100 мг.
Спосіб застосування. Ераксис застосовують внутрішньовенно краплинно. Ераксис не повинен застосовуватись у вигляді болюсної ін`єкції.
Ераксис має бути відновлений водою для ін`єкцій до концентрації 3,33 мг/мл і потім розведений до концентрації 0,77 мг/мл. Інструкція з відновлення лікарського засобу перед його застосуванням описана у підрозділі «Підготовка препарату до застосування».
Підготовка препарату до застосування. Ераксис повинен бути відновлений водою для ін`єкцій і потім розведений ТІЛЬКИ 0,9 % (9 мг/мл) розчином хлориду натрію для інфузій або 5 %
(50 мг/мл) розчином глюкози для інфузій. Сумісність відновленого розчину препарату Ераксис з розчинами для внутрішньовенного застосування та іншими лікарськими засобами, що вводять у вигляді внутрішньовенної інфузії, окрім 9 мг/мл (0,9 %) розчину хлориду натрію для інфузій або 5 мг/мл (5 %) розчину глюкози для інфузій, не була вивчена.
Відновлення.
Вміст кожного флакона відновлюють у асептичних умовах із 30 мл води для ін’єкцій, щоб забезпечити концентрацію 3,33 мг/мл. Час відновлення може тривати до 5 хв. Якщо після подальшого розведення в розчині визначаються видимі частки або зміна кольору, розчин не застосовують.
Розведення та інфузія.
Вміст флакона з відновленим розчином у асептичних умовах переносять в ємкість для внутрішньовенних інфузій, що містить або 9 мг/мл (0,9%) розчин хлориду натрію, або 50 мг/мл (5%) розчин глюкози для інфузій, для забезпечення концентрації анідулафунгіну 0,77 мг/мл. Нижче наведена таблиця об’ємів, необхідних для кожної дози.
Вимоги розведення для застосування препарату Ераксис
|
Доза |
Кількість одиниць упаковок |
Об’єм розчинника для відновлення |
Об’єм розчину для інфузіїА |
Загальний об’єм готової інфузіїБ |
Швидкість введення інфузії |
Мінімальна тривалість інфузії |
|
100 мг |
1 |
30 мл |
100 мл |
130 мл |
1,4 мл/хв. |
90 хв. |
|
200 мг |
2 |
60 мл |
200 мл |
260 мл |
1,4 мл/хв. |
180 хв. |
А – або 9 мг/мл (0,9 %) натрію хлориду для інфузій, або 50 мг/мл (5 %) глюкози для інфузій;
Б – концентрація інфузійного розчину 0,77 мг/мл.
Рекомендована швидкість інфузії – не вище 1,1 мг/хв, що еквівалентно 1,4 мл/хв для відновленого та розведеного розчину, згідно з інструкціями. Випадки реакцій, пов'язаних із введенням інфузії анідулафунгіну, трапляються рідко, якщо швидкість введення не перевищує 1,1 мг/хв.
Перед застосуванням препарати для парентерального введення повинні бути уважно оглянуті щоразу, коли це можливо, з метою виявлення видимих твердих часток і зміни кольору. Якщо спостерігаються тверді частки або зміна кольору, розчин не застосовують.
Будь-які залишки лікарського засобу або відходів слід утилізувати згідно з місцевими вимогами.
Пацієнти з порушенням функції нирок і печінки.
Корекція дози препарату не потрібна для пацієнтів з помірним, середнім або тяжким ступенем недостатності печінки, для пацієнтів з будь-яким ступенем недостатності нирок, включаючи пацієнтів, які перебувають на діалізі. Ераксис може бути застосований незалежно від часу проведення гемодіалізу.
Інші спеціальні групи.
Коригування дози для дорослих пацієнтів залежно від статі, маси тіла, етнічної приналежності, наявності ВІЛ-інфекції або для пацієнтів літнього віку не потрібне.
Діти.
Безпека та ефективність препарату Ераксис для дітей (віком до 18 років) не встановлені. Наявні на сьогодні дані описані в розділі «Фармакокінетика», але рекомендації з дозування дати не можна.
Передозування.
У випадку передозування можуть з`явитися побічні реакції, що описані в розділі «Побічні реакції».
Протягом клінічних випробувань повідомлялось про випадок необережного застосування навантажувальної разової дози анідулафунгіну 400 мг. При цьому не повідомлялось про клінічні прояви побічних ефектів. У дослідженні за участю 10 здорових добровольців, яким застосовували навантажувальну разову дозу 260 мг анідулафунгіну з наступним застосуванням 130 мг анідулафунгіну щодня, не було виявлено токсичності, що потребує обмеження дози. У 3 пацієнтів з 10 спостерігалися безсимптомне підвищення рівня трансамінази (у ≤ 3 рази від верхньої межі норми), що минало. Як і в будь-яких випадках передозування, використовуються загальні заходи лікування, що повинні здійснюватися за необхідності.
Ераксис не діалізується.
Побічні реакції.
Резюме профілю безпеки.
1565 пацієнтів у клінічних дослідженнях однократно і багаторазово отримували анідулафунгін внутрішньовенно: 1308 пацієнтів у дослідженнях фази 2/3 (923 пацієнти з кандидемією/інвазивним кандидозом, 355 пацієнтів з кандидозом ротової порожнини/стравоходу, 30 пацієнтів з інвазивним аспергільозом) і 257 пацієнтів у дослідженні фази 1.
Профіль безпеки анідулафунгіну базується на даних, отриманих від 840 пацієнтів з кандидемією/інвазивним кандидозом, які застосовували лікарський засіб у рекомендованих дозах 100 мг на добу в ході 9 досліджень. Спочатку в трьох дослідженнях (одне з них – порівняльне дослідження щодо флуконазолу, два інші − непорівняльні) досліджувалося 204 пацієнти; середня тривалість внутрішньовенного застосування лікарського засобу цими пацієнтами становила 13,5 доби (діапазон: 1-38 діб), а 119 пацієнтів застосовували анідулафунгін протягом ≥14 діб. У шести додаткових дослідженнях (два з них − порівняльні щодо каспофунгіну та 4 − непорівняльні) досліджувалося 636 пацієнтів, включаючи 53 пацієнти з нейтропенією та 131 пацієнта з інфекцією глибоких тканин; середня тривалість внутрішньовенного застосування лікарського засобу пацієнтами з нейтропенією та пацієнтами з інфекцією глибоких тканин у цих дослідженнях становила 10,0 діб (діапазон: 1-42 доби) і 14,0 діб (діапазон: 1-42 доби) відповідно. Побічні реакції зазвичай були від слабких до помірних і рідко призводили до відміни препарату.
Побічні реакції, пов'язані з інфузіями, що спостерігалися в клінічних дослідженнях під час застосування анідулафунгіну, приведені нижче, включаючи патологічний рум'янець, припливи, свербіж, висипання і кропив'янку.
Всі побічні реакції (MedDRA), які виникли у 840 осіб внаслідок застосування анідулафунгіну у дозуванні 100 мг, перераховані нижче.
Класифікація частоти побічних реакцій: дуже часті (≥1/10), часті (≥ 1/100 до <1/10), нечасті (≥1/1000 до <1/100), поодинокі (≥1/10000 до <1/1000), рідкісні (< 1/10000) та частота невідома (частоту не можна оцінити з наявних даних) У кожній групі за частотою побічні реакції представлені в порядку зменшення їх серйозності.
Порушення з боку системи крові та лімфатичної системи. Нечасті: коагулопатія.
Розлади з боку імунної системи. Частота невідома: анафілактичний шок, анафілактична реакція (див. розділ «Особливості застосування»).
Метаболічні та аліментарні розлади. Дуже часті: гіпокаліємія; часті: гіперглікемія.
Порушення з боку нервової системи. Часті: судоми, головний біль.
Судинні порушення. Часті:артеріальна гіпотензія, артеріальна гіпертензія;нечасті: патологічний рум'янець, припливи.
Порушення з боку респіраторного тракту,органів грудної клітки та медіастинальні порушення. Часті: бронхоспазм, диспное.
Порушення з боку шлунково-кишкового тракту. Дуже часті: діарея, нудота; часті: блювання; нечасті: біль у верхній частині живота.
Порушення з боку гепатобіліарної системи. Часті: підвищення рівня аланінамінотрансферази, підвищення рівня лужної фосфатази крові, підвищення рівня аспартатамінотрансферази, підвищення рівня білірубіну крові, холестаз; нечасті: підвищення рівня гамма-глутамілтрансферази.
Порушення з боку шкіри та підшкірної клітковини. Часті: висипання, свербіж; нечасті: кропив’янка.
Порушення з боку ниркової та сечовидільної системи. Часті: підвищення рівня креатиніну в крові.
Загальні порушення та порушення в місці введення.Нечасті: біль у місці введення препарату.
Звітування про підозрювані побічні реакції
Звітування про підозрювані побічні реакції є важливим. Це дає змогу постійно відслідковувати співвідношення ризику і користі, пов'язаних із застосуванням лікарського засобу. Спеціалістів охорони здоров'я просять звітувати про будь-які підозрювані побічні реакції.
Термін придатності. 3 роки.
Умови зберігання.
Зберігати у холодильнику (2-8 °C). Дозволяється зміна температури до 25 °С протягом 96 годин. Після зміни температурних умов зберігання порошок може бути повернений у холодильник.
Відновлений розчин.
Відновлений розчин можна зберігати при температурі до 25 °С протягом 24 годин.
Готовий розчин для інфузій.
Готовий розчин для інфузій можна зберігати при температурі до 25 °С протягом 48 годин. Також готовий розчин для інфузій можна зберігати замороженим (-20 °С) щонайменше 72години.
Несумісність. Ераксис не можна змішувати з іншими лікарськими засобами або розчинами, окрім тих, що зазначені у розділі «Спосіб застосування та дози».
Упаковка.
Порошок у флаконі. По 1 флакону в картонній упаковці.
Категорія відпуску. За рецептом.
Виробник.
Фармація і Апджон Компані /Pharmacia & Upjohn Company.
Місцезнаходження виробника та його адреса місця провадження діяльності.
7000 Портедж Роуд, Каламазу, МІ 49001, США/7000 Portage Road, Kalamazoo, MI 49001, USA.

 Кожный кандидоз: откуда он берется и как с ним бороться?
Кожный кандидоз: откуда он берется и как с ним бороться?
 Дерматомикозы: кандидоз и эпидермофитии
Дерматомикозы: кандидоз и эпидермофитии
 Кожная сыпь у взрослых: задача с множеством неизвестных
Кожная сыпь у взрослых: задача с множеством неизвестных
Кандидоз у медичній практиці
Кандидоз у медичній практиці